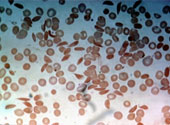
sânge

O nouă tehnologie, care constă în măsurarea debitului sangvin pentru a monitoriza anemia falciformă (siclemia), ar putea ajuta doctorii să anticipeze momentul în care pacienţii prezintă riscul unor complicaţii grave. Detalii, în continuarea articolului.
O nouă tehnologie, care constă în măsurarea debitului sangvin pentru a monitoriza anemia falciformă (siclemia), ar putea ajuta doctorii să anticipeze momentul în care pacienţii prezintă riscul unor complicaţii grave. Detalii, în continuarea articolului.
În urmă cu mai bine de 60 de ani, oamenii de ştiinţă au descoperit cauza principală a bolii cu celule în formă de seceră (siclemie sau anemie falciformă). La nivelul vasele de dimensiuni mici (capilare) ale persoanelor diagnosticate cu această tulburare se pot produce ocluzii datorate hematiilor în formă de semilună. Acest lucru nu se întâmplă în mod obişnuit în cazul hematiilor în formă de disc. Consecinţa poate fi apariţia unor dureri severe, afectarea organelor majore şi o durată de viaţă semnificativ scăzută a hematiilor de acest fel.
Cercetătorii au descoperit ulterior că boala este consecința mutaţiei unei singure proteine a hemoglobinei şi au realizat că forma de seceră - întâlnită mai des la persoanele din zonele cu climă tropicală - este de fapt o adaptare evolutivă, care poate ajuta la protejarea împotriva malariei.
Totuşi, contrar celor învăţate de oamenii de ştiinţă despre boala care afectează 13 de milioane de oameni din întreaga lume, există puţine tratamente disponibile. "Noi încă nu dispunem de terapii suficient de eficiente şi nu cunoaştem cu exactitate modalităţile diferite de manifestare ale bolii la persoane diferite", susţin Sangeeta Bhatia, Ioan şi Dorothy Wilson, Profesor de ştiințe medicale, tehnologie, inginerie electrică şi informatică la ITM.
Bhatia, cercetătorul postdoctoral David Wood şi colegii săi de la Universitatea Harvard, Massachusetts General Hospital (MGH) alături de Brigham şi Women Hospital au elaborat acum un test simplu de sânge care poate prezice dacă pacienţii cu siclemie prezintă un risc crescut de a dezvolta complicaţii dureroase ale bolii. Pentru a efectua testul, cercetătorii analizează cât de bine circulă fluxul de sânge prin intermediul unui dispozitiv microfluidic.
Aparatul, descris pe 1 martie, în revista Science Translational Medicine, ar putea ajuta medicii să monitorizeze pacienţii cu boală cu celule în formă de seceră şi să determine cea mai bună modalitate de tratament, spune Bhatia. Acesta ar putea fi util, de asemenea, cercetătorilor în dezvoltarea unor noi medicamente pentru tratamentul bolii.
Monitorizarea fluxului sangvin
Pacienţii care suferă de boală cu celule în formă de seceră sunt adesea anemici, din pricina faptului că globulele roşii malformate nu supravieţuiesc foarte mult timp în circulaţie. Cu toate acestea, cele mai multe dintre simptomele asociate bolii sunt cauzate de crize vaso-ocluzive, care apar atunci când celulele în formă de seceră, care sunt mai rigide şi mai aderente decât celulele sanguine normale, blochează vasele şi implicit fluxul de sânge. Frecvenţa şi severitatea acestor crize variază între pacienţi şi nu există nici o modalitate de a prezice când se va produce.
"Când un pacient are colesterolul ridicat, puteţi monitoriza riscul de boală cardiacă şi răspunsul la tratament, cu ajutorul unui test de sânge. Când vine vorba de boala cu celule în formă de seceră, în ciuda faptului că pacienţii prezintă aceeaşi modificare genetică la bază, unii suferă enorm în timp ce alţii nu suferă deloc - şi noi încă nu dispunem de un test care să poată ghida medicii în luarea deciziilor terapeutice", spune Bhatia.
În 2007, Bhatia şi L. Mahadevan, un profesor de matematică aplicată la Harvard care studiază fenomenele naturale şi biologice, au început să lucreze împreună pentru a înţelege modalitatea de deplasare a celulele în seceră prin capilare. În studiul curent, cercetătorii au recreat situaţiile care pot produce o criză vaso-ocluzivă: ei au direcţionat sângele printr-un microcanal şi au redus concentraţia de oxigen, declanşând celulele în seceră să se aglomereze şi să producă obstrucţie.
Pentru fiecare probă de sânge prelevată, au măsurat timpul necesar opririi curgerii sângelui după ce a fost dezoxigenat. John Higgins de la MGH and Harvard Medical School, un autor al lucrării, a comparat probele de sânge prelevate de la pacienţii cu siclemie care se prezentaseră sau nu în serviciul medical de urgenţă al spitalului sau cărora li se administrase o transfuzie de sânge în ultimele 12 luni şi a constatat că fluxul de sânge al pacienţilor care aveau o formă mai puţin severă a bolii nu a încetinit la fel de repede ca cel al pacienţilor mai grav afectaţi.
Nici o altă măsură existentă a proprietăţilor sângelui - inclusiv concentraţia de celule roşii din sânge, fracţiunea de hemoglobină afectată sau numărul de celule albe sanguine – nu pot realiza acest tip de predicţie, spune Bhatia. Constatarea subliniază importanţa de a privi vaso-ocluzia ca rezultat al interacţiunii mai multor factori, mai degrabă decât rezultatul unei singure măsuri moleculare, spune ea.
Pentru a arăta că acest dispozitiv ar putea fi util pentru dezvoltarea de medicamente, cercetătorii au testat, de asemenea, un posibil medicament pentru boala cu celule în seceră numit 5-hidroximetil furfural, care îmbunătăţeşte capacitatea hemoglobinei de a se lega de oxigen. Adăugând medicamente în torentul circulator, au remarcat îmbunătăţirea dramatică a modului de curgere prin dispozitiv.
Franklin Bunn, director de cercetare în hematologie de la Brigham and Women’s Hospital, care nu a participat la acest studiu, spune că dispozitivul s-ar putea dovedi foarte util pentru producerea de medicamente. "Acesta oferă un mod obiectiv de a evalua noi medicamente, care sperăm că va continua să fie dezvoltate pentru a combate boala cu celule în formă de seceră".
Cercetătorii au depus documentele pentru obţinerea unui brevet în tehnologiei şi lucrează în prezent la dezvoltarea unui instrument de diagnosticare şi cercetare.
Traducere după sickle-cell-blood-flow-0301
Traducerea: Ecaterina Pavel
